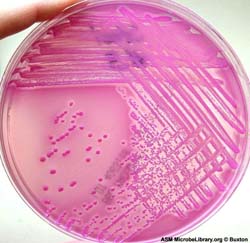
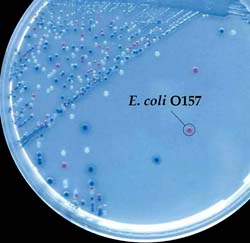
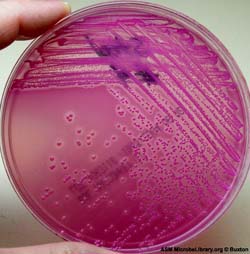

Tiêu chảy nhiễm khuẩn (TCNK) là 1 loại ỉa chảy cấp do ống tiêu hóa bị nhiễm vi khuẩn , độc tố hoặc bị nhiễm virus. TCNK có thể xảy ra ở mọi lứa tuổi, mức độ nặng của bệnh liên quan đến sự mất nước , đặc biệt ở trẻ nhỏ và người già. TCNK có thể tản phát hay thành dịch, dịch lớn hay dịch nhỏ. Ở các nước đang phát triển đây là bệnh phổ biến có thể gây thành dịch lớn, còn ở các nước phát triển, bệnh có tính chất lẻ tẻ dưới dạng nhiễm trùng nhiễm độc thức ăn trong gia đình, ở nhà trẻ, bệnh viện, nhà ăn tập thể.
Tìm ra nguyên nhân bệnh gây tiêu chảy nhiễm trùng rất khó, ngay cả những cơ sở có trang bị xét nghiệm tương đối hiện đại. Theo thông báo của tổ chức y tế thế giới, hiện nay các nước đang phát triển phân lập được mầm bệnh ở 50% trẻ em nằm viện. Ở phần lớn các nước châu Á và châu Phi chỉ tìm thấy Vibrio cholerae trong 5 -10% các trường hợp tiêu chảy cấp, còn hơn 90% rất khó chẩn đoán phân biệt trên lâm sàng. Trái lại, đối với một số nước, khoảng 12 % trẻ không tiêu chảy có chứa vi khuẩn gây bệnh.
Nguyên nhân
a. Nhiễm trùng nhiễm độc thức ăn : Đây là nguyên nhân thường gặp, ngay ở các nước có mức sống cao, do ăn phải thức ăn bị lây nhiễm vi khuẩn hay độc tố của chúng, trong một số trường hợp (nhiễm trùng nhiễm độc thức ăn do Salmonella) bệnh lý liên quan với sự xâm nhập của vi khuẩn vào niêm mạc ruột. Trong những trường hợp khác, chỉ do độc tố đã được vi khuẩn giải phóng ra trong thức ăn, không có sự nhân lên của vi khuẩn ở trong ruột hay nếu có là thứ phát.
|
Salmonella dưới kính hiển vi điện tử |
- Nhiễm trùng nhiễm độc thức ăn do Salmonella: type huyết thanh thường gặp là S. typhi murium, S. enteritidis, số lượng vi khuẩn đủ để gây bệnh thường >100.0000, thức ăn bị nhiễm thường gặp là trứng không được nấu chín.
- Nhiễm trùng nhiễm độc thức ăn do tụ cầu: nhiễm trùng nhiễm độc thức ăn do độc tố tụ cầu, là loại độc tố chịu nhiệt, thức ăn thường bị lây nhiễm bởi người mang tụ cầu vàng.
b. Iả chảy với hội chứng lỵ
- Shigella: gây lỵ trực trùng .
- E .coli: có 3 nhóm E. coli gây ỉa chảy xâm nhập với hội chứng lỵ:
+ EIEC (E. coli Entero-invasive) bệnh xảy ra ở trẻ em, người lớn, với hội chứng lỵ như lỵ trực trùng.
+ EPEC (E. coli Entero pathogenic), trước đây, nó là tác nhân gây các dịch ỉa chảy nhất là ở trẻ em trong các nhà trẻ, mẫu giáo nhưng hiện nay nó ít phân lập được ở bệnh nhân ỉa chảy. Điều trị kháng sinh là cần thiết ở trẻ nhỏ.
+ EHEC (E. coli Entero Hemorragique colitis): gây ỉa chảy phân nhầy máu.
c. Hội chứng iả chảy không thâm nhập niêm mạc ruột.
- Bệnh tả: do Vibrio Eltor, bệnh xảy ra ở nhiều nơi trên thế giới nhất là các nước chậm phát triển, bệnh phát thành dịch xảy ra hàng loạt do nguồn nước bị nhiễm độc, hoặc thực phẩm bị ruồi nhặng bám vào
- Iả chảy do E. coli Entero toxinogene (ECET). Những ECET tạo ra Enterotoxine LT và/hoặc ST chúng gây iả chảy ở trẻ em và người lớn như tả. Bệnh xảy ra rải rác muà hè ở các nước ôn đới hoặc quanh năm ở các nước nhiệt đới .
d. Iả chảy do nguồn gốc virus: Chiếm một tỷ lệ khá cao ở trẻ em dưới 2 tuổi. Ỉa chảy do nguồn gốc virus hay xảy ra vào muà đông, thường do Rotavirus, thường kèm theo nhiễm trùng đường hô hấp hoặc kèm theo hội chứng màng não .
Như vậy tác nhân ỉa chảy nhiễm khuẩn chủ yếu thuộc họ vi khuẩn đường ruột (Enterobacteriaceae), tụ cầu vàng và Rotavirus
Salmonella
Mặc dù hiện nay người ta đã biết đến mấy chục loài với hàng nghìn typ huyết thanh khác nhau thuộc giống Salmonella, S.typhi vẫn là loài được quan tâm nhiều nhất không những bởi vai trò gây bệnh của nó mà còn bởi nó gắn liền với những mốc lịch sử quan trọng trong quá trình nghiên cứu về Salmonella nói chung và bệnh thương hàn nói riêng.
Bệnh thương hàn đã biết đến từ rất lâu. Y học thế giới đã ghi nhận sự mô tả về bệnh này lần đầu tiên vào năm 1982 của Bretonneau.
Năm 1880, Grafky đã mô tả hình ảnh vi khuẩn quan sát được trên tiêu bản làm từ hạch của bệnh nhân bị chết vì bệnh thương hàn và ông cũng là người đầu tiên phân lập được S.typhi vào năm 1884.
Năm 1896, Widal chứng minh rằng huyết thanh của bệnh nhân thương hàn có khả năng làm ngưng kết S. typhi. Đây là cơ sở cho việc áp dụng phương pháp chẩn đoán huyết thanh học. Để ghi nhớ công lao của Widal, các nhà vi sinh đã lấy tên ông đặt tên cho phản ứng ngưng kết phát hiện kháng thể chống vi khuẩn thương hàn trong huyết thanh là phản ứng Widal.
Năm 1917, Felix đã mô tả kháng nguyên thân và kháng nguyên lông của Salmonella, đặt cơ sở cho phương pháp phân tích kháng nguyên của vi khuẩn.
Năm 1935, Reilly đã tiến hành nghiên cứu về cơ chế bệnh sinh của bệnh thương hàn. Ông chứng minh rằng hệ thần kinh thực vật có vai trò trong việc gây ra những tổn thương ở ruột như gây loét mảng payer.
1. Đặc điểm sinh học
1.1. Hình thái
Salmonella là trực khuẩn Gram (-), kích thước trung bình 3,0 x 0,5 µm, có nhiều lông ở xung quanh thân, trừ S.gallinarum và S.pullorum (gây bệnh ở gà vịt).
1.2. Tính chất nuôi cấy  |
Salmonella phát triển trên thạch máu |
Hiếu kỵ khí tùy tiện, phát triển được trên các môi trường nuôi cấy thông thường, có thể mọc trên một số môi trường có chất ức chế chọn lọc được dùng trong phân lập vi khuẩn này từ phân.
- Trên môi trường lỏng: sau 5-6h nuôi cấy, vi khuẩn làm đục nhẹ môi trường, sau 18h môi trường đục đều.
- Trên môi trường thạch thường: khuẩn lạc tròn, lồi, bóng, không màu hoặc màu trắng xám.
- Trên môi trường phân lập SS: khuẩn lạc có màu hồng
1.3. Tính chất sinh vật hóa học
Salmonella không lên men lactose, lên men đường Glucose thường sinh hơi. Sử dụng được citrat ở môi trường Simomons. Catalase (+), oxidase (-). Lysindecarboxylase (+), onPG (-), urease (-), RM (+), VP (-), H2S (-), indol (-).
Tuy nhiên không phải bất kỳ loài nào cũng có đầy đủ các tính chất trên. Những ngoại lệ đã được xác định cần phải biết là: S.typhi lên men đường glucose không sinh hơi và citrat Simmon (-). Trong loài S.paratyphi A chỉ có một số chủng sinh H2S và ở loài này kết quả thử citrat Simmon (-), lysindecarboxylase (-). S.arizona lên men lactose (tuy có chậm) và onPG (-).
 | |
Salmonella trên thạch McConkey | Salmonella sp. sau 24h trên thạch XLD |
1.4. Kháng nguyên
1.4.1. Kháng nguyên O
Kauffmann và White là những người đã nghiên cứu một cách hệ thống cấu trúc kháng nguyên O của Salmonella. Các tác giả đã chỉ ra gần 70 yếu tố kháng nguyên O khác nhau. Mỗi nhóm mang một yếu tố kháng nguyên đặc hiệu nhóm:
Nhóm | Yếu tố kháng nguyên đặc hiệu |
A | 2 |
B | 4 |
C | 6 |
D | 9 |
E | 3 |
Mỗi loài mang một yếu tố khác nhau, những yếu tố đó cấu tạo thành công thức O của từng loài.
1.4.2. Kháng nguyên H
Hầu hết Salmonella đều có kháng nguyên H trừ S.gallinarum và S.pullorum.
Kháng nguyên H của Salmonella có thể có tính đặc hiệu đơn hoặc kép. Những loài Salmonella có kháng nguyên H mang tính đặc hiệu đơn khi gặp kháng huyết thanh tương ứng sẽ mất khả năng di động. Ví dụ: S.typhi chỉ có kháng nguyên H gọi là d; S.paratyphi A chỉ có một kháng nguyên H gọi là a.
Một số Salmonella có kháng nguyên H mang tính đặc hiệu kép. Khi nuôi cấy chúng trong môi trường có kháng huyết thanh tương ứng với kháng nguyên H này thì nó vẫn di động và biểu hiện tính đặc hiệu của kháng nguyên H kia.
1.4.3. Kháng nguyên K
Kháng nguyên K chỉ có ở S. typhi và S. paratyphi C và được gọi là kháng nguyên Vi (Virulnece). Kháng nguyên Vi dưới dạng một lớprất mỏng không quan sát được bằng kính hiển vi quang học thông thường. Tuy nhiên kháng nguyên Vi có thể bao phủ kín kháng nguyên O, trong trường hợp này vi khuẩn sẽ không ngưng kết O xuất hiện, cần phải đun nóng huyền dịch vi khuẩn (100oC/20 phút) để tách kháng nguyên K ra khỏi tế bào.
1.5. Phân loại
1.5.1. Phân loại khoa học:
Về phân loại khoa học Salmonella được xếp vào:
- Giới : Bacteria
- Ngành: Proteobacteria
- Lớp: Gramma Proteobacteria
- Bộ: Enterobacteriales
- Họ: Enterobacteriaceae
- Giống: Salmonella lignieres 1900
- Loài: S. bongori & S. enterica
1.5.2. Phân loại theo cấu trúc kháng nguyên:
Dựa vào cấu trúc kháng nguyên, Salmonella được chia thành các nhóm, các loài và các typ huyết thanh. Lúc đầu, các Salmonella được đặt tên theo hội chứng lâm sàng mà chúng gây ra như S. typhi và các S. paratyphi A, B, C (typhoid = bệnh thương hàn), hoặc theo vật chủ như S. typhimurium gây bệnh ở chuột (murine =chuột). Về sau, người ta thấy rằng một loài Salmonella có thể gây ra một số hội chứng và có thể phân lập được ở nhiều loài động vật khác nhau. Vì những lý do đó, cuối cùng người ta gọi các loài mới phát hiện được theo tên địa phương ở đó nó được phân lập như S. teheran, S. congo, S.london.
Đến nay, người ta đã phát hiện được trên 1500 typ huyết thanh Salmonella
2. Khả năng và cơ chế gây bệnh
2.1. Khả năng gây bệnh
Tùy theo từng loài, Salmonella có thể chỉ gây bệnh cho người, chỉ gây bệnh cho động vật, nhưng cũng có thể vừa gây bệnh cho người vừa gây bệnh cho động vật
Những loài Salmonella có thể gây bệnh cho người được quan tâm nhiều hơn cả:
- S. typhi: loài này chỉ gây bệnh cho người, nó là vi khuẩn quan trọng nhất trong các căn nguyên gây bệnh thương hàn.
- S. paratyphi A: cũng chỉ gây bện cho người, là căn nguyên gây bệnh thương hàn, tỷ lệ phân lập đứng sau S. typhi.
- S. paratyphi B: chủ yếu gây bệnh cho người, nhưng có thể gây bệnh cho động vật. Tại các nước châu Âu, tỷ lệ phân lập cao hơn ở nước ta .
- S. paratyphi C: vừa có khả năng gây bệnh thương hàn, vừa có khả năng gây bệnh viêm dạ dày – ruột và nhiễm khuẩn huyết, thường gặp ở các nước Đông Nam Á.
- S. typhimurium và S. enteritidis: vừa có khả năng gây bệnh cho người vừa có khả năng gây bệnh cho động vật. Có thể gặp ở các nước khác nhau trên thế giới, chúng là căn nguyên chủ yếu của bệnh nhiễm khuẩn nhiễm độc thức ăn do Salmonella.
- S. choleraesuis: là nguyên nhân thường gặp trong các nhiễm khuẩn huyết do Salmonella ở nước ta
2.2. Cơ chế gây bệnh thương hàn
Bệnh thương hàn do S. typhi và các S. paratyphi A, B, C gây ra
Vi khuẩn xâm nhập vào cơ thể theo đường tiêu hóa do thức ăn, nước uống bị nhiễm bẩn. Số lượng vi khuẩn đủ để gây bệnh khoảng 105 đến 107.
Sau khi vào ống tiêu hóa, vi khuẩn thương hàn bám vào niêm mạc ruột non rồi xâm nhập qua niêm mạc ruột vào các hạch mạc treo ruột. Ở đây vi khuẩn nhân lên rồi qua hệ thống bạch huyết và ống ngực đi vào máu, lúc này các dấu hiệu lâm sàng bắt đầu xuất hiện. Từ máu, vi khuẩn đến lách và các cơ quan khác, tới gan theo mật đổ xuống rồi được đào thải qua phân; tới thận, một số vi khuẩn được đào thải ra ngoài theo nước tiểu; tới mảng payer, vi khuẩn tiếp tục nhân lên.
Vi khuẩn thương hàn gây bệnh bằng nội độc tố. Nội độc tố kích thích thần kinh giao cảm ở ruột gây ra hoại tử chảy máu và có thể gây thủng ruột, vị trí tổn thương thường ở các mảng payer. Đây là biến chứng hay gặp do bệnh nhân ăn sớm chưa bình phục, nhất là các thức ăn cứng.
Nội độc tố theo máu lên kích thích trung tâm thần kinh thực vật ở não thất ba. Giai đoạn toàn phát thân nhiệt tăng cao, sốt “hình cao nguyên”. Thân nhiệt tăng nhưng nhịp tim không tăng. Bệnh nhân thường có dấu hiệu li bì, có thể hôn mê, trụy tim mạch, tử vong.
Những bệnh nhân qua khỏi, sau khi đã hết các triệu chứng lâm sàng khoảng 5% vẫn tiếp tục thải vi khuẩn qua phân do vi khuẩn vẫn tồn tại trong túi mật. Tình trạng này có thể kéo dài nhiều năm. Họ trở thành nguồn lây bệnh rất nguy hiểm.
2.3. Nhiễm khuẩn và nhiễm độc thức ăn
Bệnh xảy ra do thức ăn bị nhiễm Salmonella, thường do thức ăn không được bảo quản trong tủ lạnh.
|
Salmonella được phân lập từ các đại thực bào nhiễm độc |
Thời gian ủ bệnh trung bình từ 10 đến 48h (đây là điểm khác biệt rất cơ bản với nhiễm độc thức ăn do tụ cầu, thời gian ủ bệnh rất ngắn, chỉ vài giờ). Sau thời gian ủ bệnh, bệnh nhân có sốt, nôn và ỉa chảy. Ở người lớn, rối loạn tiêu hóa thường kéo dài từ 2 đến 5 ngày rồi tự khỏi. Một số rất ít bệnh nhân trở thành người lành mang vi khuẩn, có thể kéo dài nhiều tháng.
Một số loài Salmonella chỉ gây nhiễm khuẩn nhiễm độc thức ăn ở người lớn lại có thể gây ra tình trạng bệnh lý rất nặng ở trẻ nhỏ và trẻ sơ sinh. Bệnh nhi có thể bị nhiễm khuẩn huyết, viêm màng não, viêm xương, có thể gây ra các vụ dịch ở khoa nhi.
3. Miễn dịch
Sau khi mắc bệnh thương hàn, trong huyết thanh của bệnh nhân có các kháng thể chống lại kháng nguyên O, H (và cả kháng nguyên Vi đối với những bệnh do S. typhi và S. paratyphi C). Tuy nhiên, ngày nay người ta thấy vai trò bảo vệ của các kháng thể trong huyết thanh không đầy đủ. Kháng thể lớp IgA trong dịch tiết tại chỗ có vai trò rất quan trọng trong cơ chế bảo vệ.
Người ta cũng có những bằng chứng về miễn dịch qua trung gian tế bào chống Salmonella. Tế bào lympho ở tổ chức bạch huyết tại ruột có khả năng đề kháng tự nhiên đối với Salmonella. Cơ chế đề kháng kiểu ADCC cũng được nói đến.
4. Chẩn đoán vi sinh vật bệnh thương hàn
4.1. Chẩn đoán trực tiếp
4.1.1. Nhuộm soi trực tiếp từ bệnh phẩm
Nhuộm soi trực tiếp từ phân ít có giá trị chẩn đoán. Thường tiến hành nhuộm đếm mật độ bạch cầu đa nhân để định hướng chẩn đoán. Trong bệnh thương hàn, mật độ bạch cầu đa nhân trong phân khoảng 20/một vi trường (độ phóng đại x400).
4.1.2. Cấy máu
Cấy máu được tiến hành lúc bệnh nhân đang sốt cao, cần lấy máu trước khi điều trị kháng sinh. Lấy 5 đến 10 ml máu tĩnh mạch cấy vào canh thang (thường dùng canh thang có mật bò), ủ ở 37oC. Vi khuẩn thương hàn thường mọc sau 24 đến 48h.
Khi thấy có vi khuẩn mọc, tiến hành nhuộm Gram, xem hình thể và tính chất bắt màu, cấy chuyển sang môi trường đặc, quan sát tính chất khuẩn lạc, kiểm tra tính chất sinh vật hóa học, cuối cùng xác định tính công thức kháng nguyên bằng kháng huyết thanh mẫu.
Nếu chưa điều trị kháng sinh, ở tuần lễ đầu, tỷ lệ cấy máu dương tính đến 90%, tuần thứ 2 khoảng 70- 80%; tuần thứ 3 khoảng 40- 60%. Cấy máu dương tính cho phép chúng ta xác định chắc chắn bệnh nhân mắc bệnh thương hàn.
4.1.3. Cấy phân
Trong phân có rất nhiều loại vi khuẩn, vì vậy, bệnh phẩm cần được cấy vào môi trường có chất ức chế chọn lọc như môi trường SS (Salmonella – Shigella), môi trường istrati, môi trường Endo, môi trường DCL…Trong những môi trường này có đường lactose và các chỉ thị màu giúp cho việc phân biệt vi khuẩn lên men và không lên men lactose. Để tránh bỏ sót những trường hợp phân có ít mầm bệnh, trong thực tế, ngoài việc cấy trực tiếp vào môi trường có chất ức chế chọn lọc, còn cấy vào môi trường tăng sinh. Sau khi vi khuẩn mọc, chọn khuẩn lạc nghi ngờ nhuộm soi, xác định tính chất sinh vật hóa học, xác định tính chất kháng nguyên.
Chỉ riêng cấy phân, dù phân lập được vi khuẩn cũng không cho phép ta xác định chắc chắn bệnh nhân mắc bệnh vì người lành cũng có thể mang vi khuẩn thương hàn.
Cấy phân ngoài mục đích chẩn đoán bệnh còn có giá trị kiểm tra sau khi bệnh nhân đã hết các dấu hiệu lâm sàng có còn tiếp tục đào thải vi khuẩn nữa hay không.
4.2. Chẩn đoán gián tiếp
Tiến hành phản ứng Widal để xác đinh kháng thể trong huyết thanh. Sau khinhiễm Salmonella 7- 10 ngày, trong máu sẽ xuất hiện kháng thể O, sau 12- 14 ngày xuất hiện kháng thể H. Thời gian tồn tại kháng thể trong máu trung bình là 3 tháng đối với kháng thể O và 1 đến 2 năm đối với kháng thể H.
5. Phòng bệnh
5.1. Phương pháp phòng bệnh chung không đặc hiệu
Các biện pháp chủ yếu:
- thực hiện vệ sinh ăn uống: ăn chín, uống sôi, rửa tay trước khi ăn, diệt ruồi
- cung cấp và sử dụng nước sạch
- quản lý và xử lý phân
- phát hiện người lành mang vi khuẩn, lưu ý những người có liên quan trực tiếp đến ăn uống của tập thể
- chẩn đoán sớm và cách ly bệnh nhân kịp thời, xử lý chất thải của bệnh nhân
- đối với súc vật bị bệnh: chữa triệt hoặc giết
5.2. Phương pháp phòng bệnh đặc hiệu
Trước đây người ta sử dụng vacxin TAB, đây là 1 loài vacxin chết. 1ml vacxin này chứa khoảng 1 tỷ S. typhi, 250 triệu S. paratyphi A và 250 triệu S. paratyphi B. Vacxin TAB được đưa vào cơ thể qua đường tiêm, hiệu lực không cao và chỉ duy trì được 6 tháng.
Ngày nay, nhiều phòng thí nghiệm trên thế giới đang nghiên cứu loại vacxin sống, giảm độc lực, đưa vào cơ thể bằng đường uống để kích thích miễn dịch tiết tại ruột. Loại vacxin này được thử nghiệm ở một số nước nhưng kết quả được công bố khác nhau khá nhiều.
6. Điều trị
Những kháng sinh thường được dùng để điều trị Salmonella là chloramphenicol và ampicillin. Trước đây, chloramphenicol là loại kháng sinh có hiệu lực gần như tuyệt đối trong điều trị các Salmonella nói chung và các Salmonella gây bệnh thương hàn nói riêng. Hiện nay, tỷ lệ Salmonella kháng thuốc ngày càng tăng. Ở nước ta, những năm gần đây đã xuất hiện những vụ dịch thương hàn do vi khuẩn kháng thuốc gây nên. Theo kết quả của Chương trình quốc gia giám sát tính kháng thuốc của các loại vi khuẩn gây bệnh công bố năm 1999, đã có tới 40% S. typhi (phân lập năm 1998) kháng lại ampicillin và 62% kháng lại chloramphenicol.
Vi khuẩn lỵ (Shigella)
Shigella là tác nhân gây ra bệnh lỵ trực khuẩn. Đây là một bệnh rất hay gặp ở nước ta, có thể rải rác thường xuyên hoặc gây thành các vụ dịch địa phương.
Shigella đã được Chantemesse mô tả từ năm 1888 và Shiga phân lập lần đầu tiên năm 1898 (vi khuẩn này về sau mang tên Shigella shiga). Năm 1900, Flexner và Strong đã phân lập được một tác nhân gây bệnh lỵ trực khuẩn có những tính chất khác với vi khuẩn do Shiga phân lập
1. Đặc điểm sinh học
|
Shigella dưới kính hiển vi điện tử |
1.1. Hình thái
Shigella là trực khuẩn mảnh, bắt màu Gram
(-), dài từ 1-3 µm, khi mới nuôi cấy có dạng cầu trực khuẩn. Shigella không có lông, không có vỏ và không sinh nha bào
1.2. Tính chất nuôi cấy
Như các vi khuẩn đường ruột khác, Shigella là vi khuẩn hiếu kỵ khí tùy tiện nhưng phát triển rất tốt trong điều kiện hiếu khí.
Trên môi trường đặc, chúng tạo thành khuẩn lạc tròn, lồi, bờ đều, trong và có đường kính khoảng 2mm sau 24h. Trên môi trường phân lập có lactose, khuẩn lạc vẫn không màu.
1.3. Tính chất sinh vật hóa học
Tất cả các Shigella đều lên men đường glucose, hầu hết không sinh hơi, một số trường hợp có sinh hơi nhưng rất yếu. Các Shigella không lên men lactose, trừ S. sonnei có khả năng lên men lactose chậm sau từ 2 ngày đến 2 tuần. Các Shigella flexneri, Shigella boydii và Shigella sonnei có khả năng lên men monnitol; S. dysenteriae không có khả năng này. Shigella không sinh H2S, không sử dụng được citrat trong môi trường Simmons, không sinh indol.
1.4. Độc tố
Các Shigella đều có nội độc tố và một số Shigella có ngoại độc tố.
- Nội độc tố: Nội độc tố có tính độc mạnh, cấu tạo như kháng nguyên thân, là loại kháng nguyên yếu. Tác dụng chủ yếu là gây phản ứng trong ruột.
- Ngoại độc tố: Độc tố này rất độc, mạnh như độc tố của trực khuẩn uốn ván, có tác dụng đặc hiệu vào hệ thần kinh.
1.5. Cấu trúc kháng nguyên
Tất cả các Shigella đều có kháng nguyên thân O, một số có kháng nguyên K và tất cả đều không có kháng nguyên H.
 | |
Shigella trên thạch HE, khuẩn lạc tròn, bờ đều và trong | Nuôi cấy Shigella trên thạch McConKey |
1.6. Phân loại
1.6.1. Phân loại khoa học:
Về phân loại khoa học Shigella được xếp vào:
- Giới : Bacteria
- Ngành: Proteobacteria
- Lớp: Gramma Proteobacteria
- Bộ: Enterobacteriales
- Họ: Enterobacteriaceae
- Giống: Shigella Castellani & Chalmers 1919
- Loài (có 4 loài): S. boydii, S. dysenteriae, S. flexneri, S. sonnei
1.6.2. Phân loại theo kháng nguyên:
Dựa trên tính đặc hiệu của kháng nguyên thân O và một số tính chất sinh vật hóa học, người ta chia các Shigella thành 4 nhóm: Nhóm A (S. dysenteriae), nhóm B (S.flexneri), nhóm C (S. boydii) và nhóm D (S. sonnei).
1.6.1. S. dysenteriae
Không lên men mannitol, có 10 typ huyết thanh, các typ huyết thanh không có quan hệ về kháng nguyên với các nhóm khác và không có quan hệ về kháng nguyên với nhau. Typ 1 (S. dysenteriae) còn có tên là trực khuẩn Shiga. S.shiga ngoài độc tố còn sinh ra một ngoại độc tố mạnh.
1.6.2. S. flexneri
Có khả năng lên men mannitol trừ một vài ngoại lệ. Có 6 typ huyết thanh, các typ huyết thanh này có cả thành phần kháng nguyên đặc hiệu typ và thành phần kháng nguyên chung cho cả 6 typ.
1.6.3. S. boydii
Có khả năng lên men mannitol trừ một vài ngoại lệ. Được chia thành 15 typ huyết thanh.
1.6.4. S. sonnei
Có khả năng lên men mannitol, là nhóm duy nhất có khả năng lên men lactose nhưng chậm, chỉ có 1typ huyết thanh.
2. Khả năng và cơ chế gây bệnh
Shigella là tác nhân gây bệnh lỵ trực khuẩn. Chỉ có người và khỉ mắc bệnh này. Trực khuẩn lỵ theo thức ăn nước uống vào đường tiêu hóa, cũng có trường hợp do tay bẩn, thường gặp ở trẻ em. Chỉ cần số lượng từ 102 đến 103 vi khuẩn đã có thể gây bệnh. Tại đường tiêu hóa, Shigella gây tổn thương đại tràng. Trực khuẩn lỵ gây bệnh nhờ khả năng xâm nhập và nội độc tố, S. shiga và S. smitzii còn có thêm ngoại độc tố. Vi khuẩn bám rồi xâm nhập vào niêm mạc đại tràng. Chúng nhân lên nhanh chóng trong lớp niêm mạc. Vi khuẩn chết giải phóng ra nội độc tố gây xung huyết, xuất tiết, tạo những ổ loét và mảng hoại tử. Nội độc tố còn tác động lên thần kinh giao cảm gây co thắt và tăng nhu động ruột. Những tác động đó làm bệnh nhân đau bụng quặn, buồn đi ngoài và đi ngoài nhiều lần, phân có nhầy lẫn máu.
|
| Vi khuẩn Shigella tấn công đường tiêu hóa gây bệnh lỵ. |
Ngoại độc tố của S.shiga và S.smitzii có độc tính với thần kinh trung ương, có thể gây viêm màng não và hôn mê. Tuy nhiên, vi khuẩn chỉ sinh ra ngoại độc tố sau khi đã xâm nhập vào niêm mạc đại tràng.
Bệnh lỵ trực khuẩn thường ở thể cấp tính. Một tỷ lệ nhỏ có thể trở thành mạn tính, những bệnh nhân này thỉnh thoảng lại bị ỉa chảy và thường xuyên thải vi khuẩn ra ngoài theo phân.
Ở nước ta, đa số trường hợp bị lỵ trực khuẩn do S. dysenteriae và S. flexneri, chỉ có một tỷ lệ nhỏ do S. boydii và S. sonnei.
3. Miễn dịch
Sau khi có quá trình nhiễm khuẩn Shigella (mắc bệnh lỵ trực khuẩn hoặc nhiễm trùng thể ẩn) trong máu xuất hiện các kháng thể đặc hiệu. Tuy nhiên hiệu lực bảo vệ của các kháng thể này rất kém.
Vai trò bảo vệ chủ yếu là nhờ IgA tiết tại ruột. Nghiên cứu về miễn dịch tiết trong bẹnh lỵ trực khuẩn đã được tiến hành rất sớm, thuộc vào những nghiên cứu đầu tiên trong lịch sử nghiên cứu miễn dịch tiết nói chung.
4. Chẩn đoán vi sinh vật
4.1. Chẩn đoán trực tiếp
4.1.1. Nhuộm soi trực tiếp
Bệnh phẩm có thể lấy sau khi bệnh nhân đã đi ngoài ra bô sạch, nên lấy ở chỗ phân có nhầy máu, hoặc lấy trực tiếp từ trực tràng, làm tiêu bản nhuộm soi xác định mật độ bạch cầu đa nhân. Ở bệnh nhân lỵ trực khuẩn, mật độ bạch cầu đa nhân trong phân rất cao, thường là 30 đến 50, có khi trên 50 trong một vi trường với độ phóng đại x400.
4.1.2. Cấy phân
 |
Shigella dưới kính hiển vi |
Cấy phân là phương pháp tốt nhất để chẩn đoán bệnh lỵ trực khuẩn. Bệnh phẩm cần phải được cấy ngay lên môi trường phân lập vì vi khuẩn lỵ chết rất nhanh sau khi ra ngoài môi trường, nên cấy trên môi trường có chất ức chế chọn lọc như: DCL, Endo, SS và không có chất ức chế chọn lọc là thạch lactose- xanh bromothymol. Sau 24h, chọn khuẩn lạc nghi ngờ, xác định tính chất sinh vật hóa học và định loại bằng các kháng huyết thanh mẫu.
4.2. Chẩn đoán gián tiếp
Phản ứng huyết thanh rất ít được làm để chẩn đoán bệnh lỵ trực khuẩn vì đây là bện cấp tính, cần chẩn đoán nhanh, mặc khác, phản ứng huyết thanh không có tính đặc hiệu cao. Tuy nhiên, chẩn đoán huyết thanh đôi khi cũng được tiến hành với những trường hợp mạn tính, cấy phân không phân lập được vi khuẩn, hoặc làm vì mục đích nghiên cứu dịch tễ học.
5. Phòng bệnh
Thực hiện các biện pháp phòng bệnh không đặc hiệu: vệ sinh ăn uống, sử dụng nước sạch, quản lý xử lý phân, diệt ruồi; chẩn đoán sớm và cách ly bệnh nhân.
Hiện nay ở nước ta chưa có vacxin phòng bệnh lỵ trực khuẩn.
6. Chữa bệnh
Shigella là một trong số các vi khuẩn có tỷ lệ kháng kháng sinh rất cao. Những chủng Shigella mang plasmid chứa các gien kháng lại nhiều kháng sinh đã được phát hiện đầu tiên ở Nhật Bản, sau đó được phát hiện ở nhiều nước khác, trong đó có nước ta. Với tình hình kháng thuốc như vậy, việc làm kháng sinh đồ để chọn kháng sinh thích hợp để điều trị là hết sức cần thiết
Escherichia coli
Escherichia do Escherich phát hiện lần đầu tiên năm 1885. Giống Escherichia được chọn là đại biểu điển hình họ vi khuẩn đường ruột. Giống này gồm nhiều loài như E. coli, E. adecarboxylase, E. blattae, E. fergusonii, E. hermanii và E. vulneris; trong số đó, E. coli có vai trò quan trọng nhất.
1.Đặc điểm sinh học
 |
Cấu tạo tế bào E. coli |
1.1. Hình thái
E. coli là trực khuẩn Gram (-), kích thước trung bình 2- 3µm x 0,5 µm; trong những điều kiện không thích hợp (ví dụ: môi trường có kháng sinh) vi khuẩn có thể rất dài như sợi chỉ. Rất ít chủng E. coli có vỏ, nhưng hầu hết có lông và có khả năng di động.
1.2. Tính chất nuôi cấy
E. coli phát triển dễ dàng trên các môi trường nuôi cấy thông thường. Một số có thể phát triển trên môi trường tổng hợp rất nghèo chất dinh dưỡng, hiếu kỵ khí tùy tiện, có thể phát triển ở nhiệt độ từ 5- 40oC.
Trong những điều kiện thích hợp E. coli phát triển rất nhanh, thời gian thế hệ chỉ khoảng 20 đến 30 phút. Cấy vào môi trường lỏng (như canh thang) sau 3- 4h đã làm đục nhẹ môi trường, sau 24h làm đục đều; sau hai ngày trên mặt môi trường có váng mỏng,những ngày sau dưới đáy ống có thể thấy cặn.
Trên môi trường thạch thường, sau 24h khuẩn lạc khoảng 1,5 mm, hình thái khuẩn lạc điển hình dạng S, nhưng cũng có thể dạng R hoặc M.
| |
Phân lập E. coli trên MacConkey | Phân lập E. coli trên CHROMagar |
1.3. Tính chất hóa sinh
E. coli có khả năng lên men nhiều loại đường và có sinh hơi. Tất cả E. coli đều lên men lactose và sinh hơi (trừ E. coli loại EIEC).E. coli có khả năng sinh indol, không sinh H2S, không sử dụng được nguồn carbon của citrat trong môi trường Simmons, có decarboxylase (vì vậy có khả năng khử carboxyl của lysin, ornitin, arginin và acid glutamic, betagalactosidase (+), VP (-).
1.4. Khángnguyên
Kháng nguyên O: người ta đã biết tới gần 160 yếu tố kháng nguyên O của E. coli.
 |
E.coli dưới kính hiển vi điện tử
|
Kháng nguyên K: khoảng 100 yếu tố kháng nguyên K đã được xác định và chia thành 3 loại: A, B và L, trong đó A dưới dạng vỏ quan sát được dưới kính hiển vi quang học thông thường, B và L dưới dạng màng rất mỏng chỉ có thể quan sát nhờ kính hiển vi điện tử.
Kháng nguyên H: hơn 50 yếu tố kháng nguyên H đã đượcxác định.
1.5. Phânloại
1.5.1. Phânloạikhoahọc
Về phân loại khoa học Shigella được xếp vào:
- Giới : Bacteria
- Ngành: Proteobacteria
- Lớp: Gramma Proteobacteria
- Bộ: Enterobacteriales
- Họ: Enterobacteriaceae
- Giống: Escherichia
- Loài: E. coli
- Tên khoa học: Escherichia coli (Migula 1985) Castellani & Chalmers 1919
1.5.2. Phân loại theo cấu trúc kháng nguyên
Dựa vào cấu trúc của kháng nguyên, E.coli được chia thành các typ huyết thanh. Với sự tổ hợp của các yếu tố kháng nguyên O, K và H sẽ có rất nhiều typ huyết thanh khác nhau. Mỗi typ huyết thanh được ký hiệu bằng kháng nguyên O và K, ví dụ: O86B7 (yếu tố kháng nguyên O số 36, yếu tố kháng nguyên K số 7 loại B.
Dựa vào tính chất gây bệnh, người ta chia E.coli thành các loại:
- EPEC (Enteropathogenic E.coli): E.coli gây bệnh đường ruột
- ETEC (Enterotoxigenic E.coli): E.coli sinh độc tố ruột
- EIEC (Enteroinvasive E.coli): E.coli xâm nhập đường ruột
- EAEC (Enteroadherent E.coli): E.coli bám dính đường ruột
- EHEC (Enterohaemorrhagic E.coli): E.coli gây chảy máu đường ruột
|
E. coli dưới kính hiển vi điện tử |
2. Khả năng và cơ chế gây bệnh
Trong đường tiêu hóa E. coli chiếm tỷ lệ cao nhất trong số vi khuẩn hiếu khí (khoảng 80%). Tuy nhiên, E. coli cũng là một vi khuẩn gây bệnh quan trọng, nó đứng đầu trong các vi khuẩn gây ỉa chảy, viêm đường tiết niệu, viêm đường mật; đứng hàng đầu trong các căn nguyên gây nhiễm khuẩn huyết. E. coli có thể gây nhiều bệnh khác như viêm phổi, viêm màng não, nhiễm khuẩn vết thương. Theo báo cáo của chương trình quốc gia giám sát tính kháng thuốc của các vi khuẩn gây bệnh thường gặp (1988- 1994) thì E. coli đứng thứ hai (sau S. aureus) về tỷ lệ phân lập được từ các loại bệnh phẩm ở nước ta.
Những typ huyết thanh có khả năng gây bệnh thường gặp trên lâm sàng là: O111B4, O867B7, O126B16, O55B5, O119B4, O127B8, O25B15, O128B12. Cơ chế gây bệnh của E. coli khác nhau tùy loại:
- ETEC: gây bệnh do ngoại độc tố LT, là loại độc tố ruột của V. cholerae. Độc tố này bám vào thụ thể ở ruột, làm giảm hấp thu Na+, tăng tiết nước và Cl-
- EIEC: gây bệnh do khả năng xâm nhập vào niêm mạc đại tràng, cơ chế gây bệnh giống vi khuẩn lỵ.
|  |
E. coli, Salmonella | , Shigella |
- EHEC: cơ chế cũng chưa hoàn toàn rõ, nhưng người ta đã xác định được một loại độc tố có cấu trúc kháng nguyên và cơ chế tác động giống với ngoại độc tố của S.shiga. Trong quá trình gây bệnh, EHEC làm tổn thương xuất huyết ở ruột.
- EPEC: cơ chế chưa được biết rõ.
3. Chẩn đoán vi sinh vật
3.1. Chẩn đoán trực tiếp
Bệnh phẩm khác nhau tùy bệnh: là phân với nhiễm khuẩn đường tiêu hóa, nước tiểu với nhiễm khuẩn đường tiết niệu, máu nếu là nhiễm khuẩn máu…
Có thể làm tiêu bản soi trực tiếp đối với một số loại bệnh phẩm như cặn ly tâm nước tiểu hoặc nước não tủy.
Phương pháp chẩn đoán chủ yếu nhất là nuôi cấy phân lập. Bệnh phẩm phân được cấy trên môi trường có chất ức chế chọn lọc như DCL, Endo. Nước tiểu giữa dòng được tiến hành cấy trên thạch thường, máu được cấy vào canh thang.
Sau khi đã phân lập được vi khuẩn thuần nhất thì tiến hành xác định tính chất sinh vật hóa học và định loại bằng kháng huyết thanh mẫu.
Đối với viêm màng não, hiện nay người ta còn tiến hành phương pháp chẩn đoán nhanh và đặc hiệu bằng kỹ thuật ngưng kết latex để xác định kháng nguyên của E. coli trong dịch não tủy.
3.2. Chẩn đoán gián tiếp
Trên thực tế chẩn đoán gián tiếp không được sử dụng để chẩn đoán các nhiễm khuẩn do E. coli
4. Phòng bệnh
Hiện nay chưa có phương pháp phòng bệnh đặc hiệu. Để đề phòng nhiễm khuẩn đường tiêu hóa do E. coli, thực hiện các biện pháp phòng bệnh chung không đặc hiệu giống như đối với các vi khuẩn đường ruột khác.
5. Chữa bệnh
E. coli thuộc vào các vi khuẩn có tỷ lệ kháng thuốc cao, nhất là các chủng phân lập được từ nước tiểu, cần làm kháng sinh đồ để chọn kháng sinh phù hợp.
Ngoài ra, bồi phụ nước, điện giải trong trường hợp ỉa chảy rất có giá trị trong điều trị
Vibrio
Giống Vibrio thuộc họ Vibrionaceae. Họ này bao gồm 5 giống, trong đó 3 giống có tầm quan trọng trong y học là Vibrio, Aeromonas và Pleisiomonas. Thuật ngữ “Vibrio” trước đây thường chỉ gắn liền với Vibrio cholerae và Vibrio parahaemolyticus. Đến nay người ta đã biết đến hơn 30 loài thuộc giống vi khuẩn này, tuy nhiên trong số đó có những loài mới được phát hiện, hiểu biết về chúng còn hạn chế và nhiều loài khả năng gây bệnh cho người chưa được xác định.
|
Cấu tạo Vibrio dưới kính hiển vi điện tử |
1.Tính chất chung
Định nghĩa: Vibrio là những vi khuẩn hình que hơi cong, di động nhờ một lông ở một đầu, hiếu khí hoặc hiếu kỵ khí tùy tiện, oxidase (+), catalase (+), lên men đường không sinh hơi, chuyển nitrat thành nitrit, cần ion Na+ (muối NaCl) cho sự phát triển.
Tất cả các loài thuộc giống Vibrio đều cần NaCl để phát triển, nhưng nồng độ tối ưu cho mỗi loài không giống nhau. Những loài cần NaCl thấp như V. cholerae, V.metschnikovii, V. mimicus và một số chủng của các loài V. fluvialis, V. furnissii, V.anguillarum; thậm chí chúng có thể phát triển ở nước pepton không cần cho thêm NaCl. Ngược lại, có những loài ở biển ưa mặn như V. alginolyticus và V.parahaemolyticus, có thể phát triển ở NaCl nồng độ 6- 8%.
Tất cả các loài có khả năng gây bệnh cho người đều phát triển được rên môi trường TCBS, sau 18- 24h hình thành khuẩn lạc với kích thước trung bình hoặc lớn, có màu vàng (nếu lên men đường sucrose) hoặc xanh (nếu không lên men đường sucrose).
Cấy bệnh phẩm vào môi trường tăng sinh, sau đó cấy chuyển sớm sang môi trường TCBS hoặc môi trường phân lập khác là thích hợp trong quá trình phân lập tất cả các Vibrio.
Thuật ngữ NAG (non- agglutiable Vibrio = Vibrio không ngưng kết) để chỉ các chủng không thuộc nhóm 01 và không gây bệnh. Hiện nay không sử dụng thuật ngữ này nữa vì những lý do sau
- Các chủng không thuộc nhóm 01 cũng có thể gây bệnh, tuy cơ chế gây bệnh khác với V. cholerae 01.
| |
Phân lập Vibrio trên MacConkey | Phân lập Vibrio trên CHROMagar |
- Từ năm 1992 xuất hiện nhóm huyết thanh mới, V. cholerae 0139, đã gây ra nhiều vụ dịch tả ở nhiều nước trên thế giới- Các V. cholerae không thuộc nhóm 01 chỉ không ngưng kết với kháng huyết thanh 01, chúng sẽ bị ngưng kết khi gặp kháng huyết thanh đặc hiệu.
2. Tính chất của V. cholerae
Thuật ngữ V. cholerae trước đây được hiểu đồng nghĩa với tác nhân gây ra bệnh tả . Hiện nay V. cholerae được hiểu là một loài bao gồm các vi khuẩn gây bệnh tả và cả những vi khuẩn không gây bệnh tả có sự giống nhau về cấu trúc của ADN, và do đó có sự giống nhau cơ bản về các tính chất sinh vật học khác.
3. Đặc điểm sinh học
3.1. Hình thái
V. cholerae là loại vi khuẩn hình que hơi cong, kích thước trung bình 2- 4 x 0,3- 0,6 µm. Vì có hình dấu phẩy nên trước đây còn gọi là V. comma. Tuy vậy khi nuôi cấy lâu ngày có thể có nhiều dạng. V. cholerae bắt màu Gram (-), không có vỏ, không sinh nha bào, có một lông ở đầu và có khả năng di động rất mạnh
3.2. Nuôi cấy
V. cholera hiếu khí, nhiệt độ thích hợp là 37oC, có thể phát triển tốt trong môi trường kiềm (pH 8,5- 9,5), có nồng độ NaCl cao (3%). Trong môi trường pepton kiềm mọc nhanh và tạo váng. Trên môi trường thạch kiềm sau 18h có thể quan sát thấy khuẩn lạc tròn, lồi nhẵn và trong suốt. Trên thạch MacConkey khuẩn lạc trong (không lên men đường lactose). Trên môi trường TCBS khuẩn lác có màu vàng vì lên men đường sucrose.
3.3. Tính chất sinh vật hóa học
Oxidase (+), indol (+), glucose (+), sucrose (+), manose (+), lactose (-), arabinose (-), H2S (-), urease (-).
3.4. Khả năng đề kháng
 |
V. cholerae dưới kính hiển vi điện tử |
V. cholerae có sức đề kháng yếu với các tác nhân lý hóa, trừ pH kiềm. Tuy nhiên có thể sống 1h trong phân và một số ngày trong nước.
4. Phân loại
4.1. Phân loại khoa học
Về phân loại khoa học V. cholerae được xếp vào:
- Giới : Bacteria
- Ngành: Proteobacteria
- Lớp: Gramma Proteobacteria
- Bộ: Vibrionales
- Lớp: Vibrionaceae
- Giống: Vibrio Pacini 1854
- Loài: Vibrio cholerae
4.2. Phân loại theo cấu trúc kháng nguyên:
Loài V. cholerae thuộc giống Vibrio, họ Vibrionaceae. Loài này có kháng nguyên lông (kháng nguyên H) giống nhau. Căn cứ vào sự khác nhau của kháng nguyên thân (kháng nguyên O), V. cholerae được phân chia thành hơn 100 nhóm.
Trước năm 1992, căn nguyên của tất cả các vụ dịch tả trên thế giới đều thuộc nhóm 01. Một số nhóm huyết thanh khác có khả năng gây ỉa chảy nhưng cơ chế không giống với V. cholerae 01 và không có khả năng gây dịch. Năm 1992 xuất hiện nhóm huyết thanh mới gây ỉa chảy với cơ chế hoàn toàn giống như V. cholerae 01 là V.cholerae 0139. Vi khuẩn này lần đầu tiên được phát hiện trong một vụ dịch ở Madras Ấn Độ, sau đó gây ra những vụ dịch lớn ở nhiều nước trên thế giới.
V. cholera 01 được chia thành 3 typ huyết thanh: Ogawa, Inaba và Hikojima
Dựa vào tính chất sinh học, vi khuẩn tả được chia thành hai typ: V. cholera sinh typ cổ điển (V. cholerae), và V. cholerae sinh typ Eltor (V. Eltor).
Sinh typ cổ điển được R.Koch phân lập lần đầu tiên năm 1883 trong một vụ dịch lớn ở Ai Cập. Sinh typ Eltor do Gotschlich phân lập đầu tiên năm 1905 từ tử thi bệnh nhân tả tại trạm cách ly Eltor, cũng như ở Ai Cập.
V. cholerae 0139 được giả thiết rằng có nguồn gốc từ V. cholerae 01, sinh typ Eltor. Một trong những điểm ủng hộ giả thiết đó là độc tố ruột của V. cholerae 0139 rất giống với độc tố ruột của V. Eltor. Tuy nhiên V. cholerae 0139 có những điểm khác với V. cholerae 01, cả sinh typ cổ điển và sinh typ Eltor về cấu trúc di truyền và một số tính chất khác. Sự khác biệt quan trọng nhất là V. cholerae 0139 không có các gen kiểm soát quá trình tổng hợp kháng nguyên 01, vì vậy nó không bị ngưng kết bởi kháng huyết thanh kháng 01.
5. Miễn dịch
5.1. Cơ chế đề kháng không đặc hiệu
Độ acid của dịch vị là yếu tố đề kháng rất quan trọng ngăn chặn vi khuẩn tả. Thực nghiệm đã chứng minh rằng nếu sự tiết dịch của dạ dày bình thường và chế độ ăn không có gì đặc biệt thì vi khuẩn tả khó có thể vượt qua được dạ dày để xuống ruột non. Hệ vi khuẩn bình thường cũng tham gia vào cơ chế đề kháng không đặc hiệu nhờ sự cạnh tranh với vi khuẩn tả.
5.2. Cơ chế đề kháng đặc hiệu
Bệnh tả có khả năng tạo nên miễn dịch khá vững bền. Những nghiên cứu ở vùng có lưu hành dịch tả cho thấy rằng, 90% số người bị mắc bệnh tả không bị mắc lại. Thời gian bảo vệ kéo dài khoảng 3 năm.
Vai trò chủ chốt tạo nên miễn dịch đặc hiệu là miễn dịch tiết tạo chỗ do các IgA tiết quyết định. Đối với cả V. cholerae 01 và 0139 đều có hai loại kháng thể có vai trò bảo vệ: kháng thể chống LPS ngăn cản độc tố này gắn vào thụ thể GM1. Tuy nhiên các kháng thể này có tính đặc hiệu khác nhau, vì vậy những người đã có miễn dịch với V.cholerae 01 vẫn bị mắc bệnh do V. cholerae 0139.
6. Khả năng và cơ chế gây bệnh
Trong điều kiện tự nhiên, vi khuẩn tả chỉ gây bệnh cho người. Vi khuẩn xâm nhập vào cơ thể bằng đường ăn uống. Để xuống ruột non , vi khuẩn phải vượt qua dạ dày. Bình thường độ pH của dạ dày xấp xỉ 3, đủ gây chết nhanh chóng vi khuẩn tả. Những thử nghiệm trên động vật và trên người tình nguyện cho thấy rằng, vi khuẩn tả chỉ gây ỉa chảy cấp nếu cho động vật thí nghiệm hoặc người tình nguyện uống natri bicarbonat ngay trước khi cho uống vi khuẩn tả. Trên thực tế, bệnh tả thường gặp ở những người có độ acid của dịch vị bị giảm hoặc mất. Đối với những người dạ dày tiết dịch bình thường thì thức ăn, nước uống phải có khả năng trung hòa bớt acid cuả dịch vị, vi khuẩn tả mới có thể gây bệnh được.
 |
Các loại mắm bán ở chợ không che đậy và có cả ruồi bu vào – yếu tố trung gian truyền bệnh tả - Ảnh: L.TH.H. |
Sau khi vượt qua được dạ dày xuống ruột non, vi khuẩn tả bám vào niêm mạc nhưng không xâm nhập sâu vào mô ruột và hầu như không gây tổn thương cấu trúc của niêm mạc ruột. Tại ruột non, vi khuẩn phát triển nhanh chóng nhờ pH thích hợp (pH xấp xỉ 8). Vi khuẩn tiết ra độc tố ruột LT (thermolabile toxin). Lt là một protein gồm 1 tiểu phần A và 5 tiểu phẩn B. Độc tố ruột gắn vào niêm mạc ruột non nhờ tiểu phần B gắn vào thụ thể GM1 của niêm mạc ruột. Tiểu phần A tác động làm hoạt hóa enzyme adenyl cyclase dẫn đến tăng quá nhiều AMP vòng, làm cho tế bào niêm mạc ruột giảm hấp thụ Na+, tăng tiết nước và Cl- gây ra ỉa chảy cấp tính. Nếu không được điều trị tích cực bệnh nhân sẽ chết vì kiệt nước và mất các chát điện giải.
7. Dịch tễ học
Nguồn lây bệnh là bệnh nhân và người lành mang mầm bệnh.Bệnh nhân bắtđầu đào thải vi khuẩn theo phân từ thời kỳ ủ bệnh. Đến thời kỳ toàn phát một số lượng lớn vi khuẩn được đào thải theo phân và chất nôn. Sau khi khỏi bệnh vi khuẩn vẫn còn tiếp tục được đào thải theo phân trong nhiều tháng. Người mang mầm bệnh không triệu chứng tuy đào thải số lượng vi khuẩn nhỏ hơn người bệnh nhưng nguy hiểm vì khó phát hiện. Mối nguy hiểm này tăng lên vì trong các vụ dịch tả tỷ lệ người lành mang vi khuẩn cao hơn hẳn người mắc bệnh.
Nước (bao gồm nước ăn và nước sinh hoạt) giữ vai trò đặc biệt trong quá trình truyền bệnh tả, những vụ dịch tả xảy ra đồng thời ở nhiều quốc gia dùng chung nước một dòng sông bị nhiễm bẩn. Những tập quán sinh hoạt lạc hậu rất dễ dàng làm nguồn nước bị ô nhiễm.
Thức ăn được xác định là yếu tố trung gian truyền bệnh quan trọng. Trong thức ăn giữ ở nhiệt độ xấp xỉ 300C vi khuẩn tả có thể sống được 1- 5 ngày, ở 5- 100C vi khuẩn tả có thể sống một vài tuần.
8. Chẩn đoán vi sinh vật
8.1. Chẩn đoán trực tiếp
Bệnh phẩm là phân và chất nôn, cần phải xét nghiệm ngay, nếu chưa được xét nghiệm trong vòng 2h thì phải cấy vào môi trường bảo quản Cary- Blair.
8.2. Nhuộm soi hoặc soi tươi
Nhuộm soi để quan sát hình thể vi khuẩn trực tiếp từ bệnh phẩm ít có giá trị. Nhuộm soi đếm bạch cầu trong phân: trong bệnh tả thường thấy số lượng ít, khoảng 5 bạch cầu trong 1 vi trường, quan sát tính di động của vi khuẩn tả dưới kính hiển vi nền đen.
8.3. Nuôi cấy phân lập:
Các môi trường thường được dùng để phân lập vi khuẩn tả là: pepton kiềm, thạch kiềm, TCBS
8.4. Kỹ thuật kháng thể huỳnh quang trực tiếp (Direct Fluorescent Antibody Test – DFA)
Làm tiêu bản từ bệnh phẩm hoặc sau khi cấy vào pepton kiềm 6-8h. Nhuộm tiêu bản bằng kháng thể gắn huỳnh quang. Rửa loại bỏ phần kháng thể huỳnh quang thừa rồi soi kính hiển vi huỳnh quang. Phương pháp này cho kết quả rất nhanh và có tính đặc hiệu cao, thường được áp dụng trong kiểm dịch ở các cửa khẩu.
Hiện nay một số nước đã sản xuất bộ chẩn đoán nhanh, theo nguyên lý kỹ thuật kháng thể huỳnh quang trực tiếp, sử dụng kháng thể đơn dòng với độ nhạy và độ đặc hiệu đạt 100%
 |
V. cholerae dưới kính hiển vi điện tử |
9. Phòng và chữa bệnh
9.1. Phòng bệnh
9.1.1. Không đặc hiệu
Những biện pháp quan trọng là: vệ sinh ăn uống, sử dụng nước sạch, quản lý và xử lý phân, diệt ruồi; chẩn đoán sớm, cách ly bệnh nhân, xử lý phân và chất nôn của bệnh nhân. Khi có dịch tả phải thông báo ngay và kịp thời thực hiện các biện pháp bao vây dập dịch
9.1.2. Đặc hiệu
Trước đây dùng vacxin chết, đưa vào cơ thể bằng đường tiêm. Hiệu lực bảo vệ của loại vacxin này không cao vì đáp ứng miễn dịch của cơ thể chủ yếu là đáp ứng kháng thể trong huyết thanh. Hiện nay đã có các loại vacxin sử dụng theo đường uống nhằm kích thích đáp ứng miễn dịch tiết tại ruột. Có 2 loại: vacxin sống giảm độc lực và vacxin chết. Một số nghiên cứu cho thấy vacxin sống giảm độc lực có khả năng tạo miễn dịch bảo vệ trên 80%, tương đương với tỷ lệ bảo vệ ở nhóm người đã bị mắc bệnh tả thể nhẹ
Vacxin phòng bệnh tả đang được dùng ở nước ta là vacxin bất hoạt gồm cả 01 và 0139. Vacxin dạng huyền dịch đưa vào cơ thể theo đường uống. Đối tượng sử dụng là những người sống trong vùng có dịch tả lưu hành, ở mọi lứa tuổi.
9.2. Chữa bệnh
Bù nước và điện giải có tầm quan trọng hàng đầu để cứu sống bệnh nhân. Cho uống ORS (oresol) và các chất lỏng khác tương đương với số nước và các chất điện giải bị mất, tiến hành truyền tĩnh mạch khi cần thiết.
Vi khuẩn tả còn nhạy cảm với nhiều kháng sinh thông thường. Để điều trị bệnh tả thường dùng tetracyclin, chloramphenicol hoặc bactrim. Tuy nhiên cũng đã có tài liệu công bố phát hiện được vi khuẩn tả kháng thuốc.